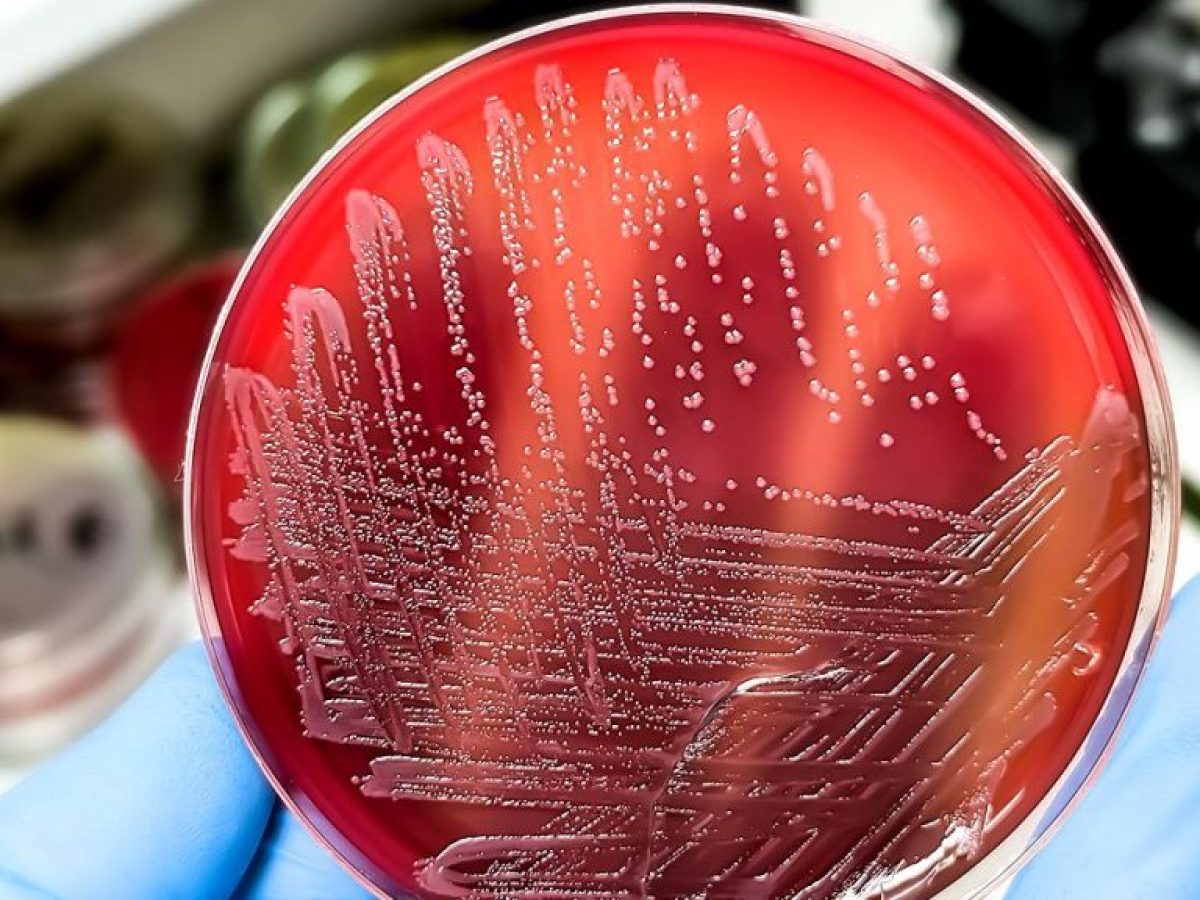

Πιθανή και στην Ελλάδα είναι η διακίνηση συμπληρώματος διατροφής, το οποίο συνδέεται με επιδημία σαλμονέλωσης στις ΗΠΑ.Eli Lilly: Προετοιμάζεται να κυκλοφορήσει το χάπι της για την παχυσαρκία
Η νέα εποχή της Καρδιοχειρουργικής: Το παράδειγμα της Ελβετίας
“Ακάλυπτοι οι νεφροπαθείς της Αίγινας”
Λιγότερο απο 1 λεπτό
Διάρκεια άρθρου:
Λεπτά
Πιθανή και στην Ελλάδα είναι η διακίνηση συμπληρώματος διατροφής, το οποίο συνδέεται με επιδημία σαλμονέλωσης στις ΗΠΑ.Eli Lilly: Προετοιμάζεται να κυκλοφορήσει το χάπι της για την παχυσαρκία
Η νέα εποχή της Καρδιοχειρουργικής: Το παράδειγμα της Ελβετίας
“Ακάλυπτοι οι νεφροπαθείς της Αίγινας”
Το πρωτότυπο άρθρο ανήκει στο iatronet.gr υγεία διατροφή ομορφιά φυσική κατάσταση ειδήσεις .